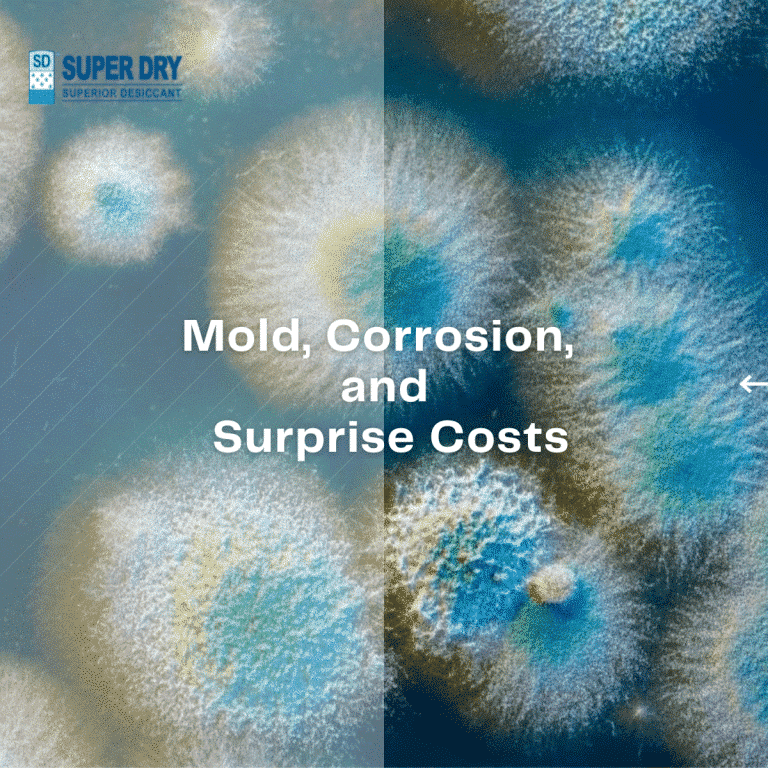

Media
All, News
04 Dec 2023
The Impact of Moisture on Shipped Goods
All, News
29 Nov 2023
SD Desiccants Explanation
All, News
27 Nov 2023
Desiccants in Asia’s Rainy Season
All, News
24 Nov 2023
Knocking Humidity with Super Dry
All, News
10 Nov 2023